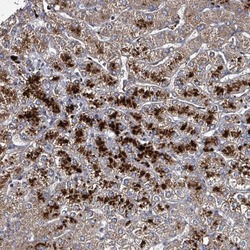

Antibody data
- Antibody Data
- Antigen structure
- References [1]
- Comments [0]
- Validations
- Immunohistochemistry [4]
Submit
Validation data
Reference
Comment
Report error
- Product number
- PA5-62150 - Provider product page

- Provider
- Invitrogen Antibodies
- Product name
- C4orf29 Polyclonal Antibody
- Antibody type
- Polyclonal
- Antigen
- Recombinant protein fragment
- Description
- Immunogen sequence: NKSGYTSRNP QSYHLLSKEQ SRNSLRKESL IFMKGVMDEC THVANFSVPV DPSLIIVVQA KEDAYIPRTG VRSLQEIWPG CEIRYL Highest antigen sequence identity to the following orthologs: Mouse - 86%, Rat - 88%.
- Reactivity
- Human
- Host
- Rabbit
- Isotype
- IgG
- Vial size
- 100 μL
- Concentration
- 0.2 mg/mL
- Storage
- Store at 4°C short term. For long term storage, store at -20°C, avoiding freeze/thaw cycles.
Submitted references Quantitative high-confidence human mitochondrial proteome and its dynamics in cellular context.
Morgenstern M, Peikert CD, Lübbert P, Suppanz I, Klemm C, Alka O, Steiert C, Naumenko N, Schendzielorz A, Melchionda L, Mühlhäuser WWD, Knapp B, Busch JD, Stiller SB, Dannenmaier S, Lindau C, Licheva M, Eickhorst C, Galbusera R, Zerbes RM, Ryan MT, Kraft C, Kozjak-Pavlovic V, Drepper F, Dennerlein S, Oeljeklaus S, Pfanner N, Wiedemann N, Warscheid B
Cell metabolism 2021 Dec 7;33(12):2464-2483.e18
Cell metabolism 2021 Dec 7;33(12):2464-2483.e18
No comments: Submit comment
Supportive validation
- Submitted by
- Invitrogen Antibodies (provider)
- Main image

- Experimental details
- Immunohistochemical analysis of C4orf29 in human testis using C4orf29 Polyclonal Antibody (Product # PA5-62150) shows strong cytoplasmic positivity in Leydig cells.
- Submitted by
- Invitrogen Antibodies (provider)
- Main image

- Experimental details
- Immunohistochemical analysis of C4orf29 in human kidney using C4orf29 Polyclonal Antibody (Product # PA5-62150) shows strong cytoplasmic granular positivity in cells in tubules.
- Submitted by
- Invitrogen Antibodies (provider)
- Main image
- Experimental details
- Immunohistochemical analysis of C4orf29 in human liver using C4orf29 Polyclonal Antibody (Product # PA5-62150) shows strong cytoplasmic granular positivity in hepatocytes.
- Submitted by
- Invitrogen Antibodies (provider)
- Main image

- Experimental details
- Immunohistochemical analysis of C4orf29 in human small intestine using C4orf29 Polyclonal Antibody (Product # PA5-62150) shows strong cytoplasmic positivity in goblet cells.